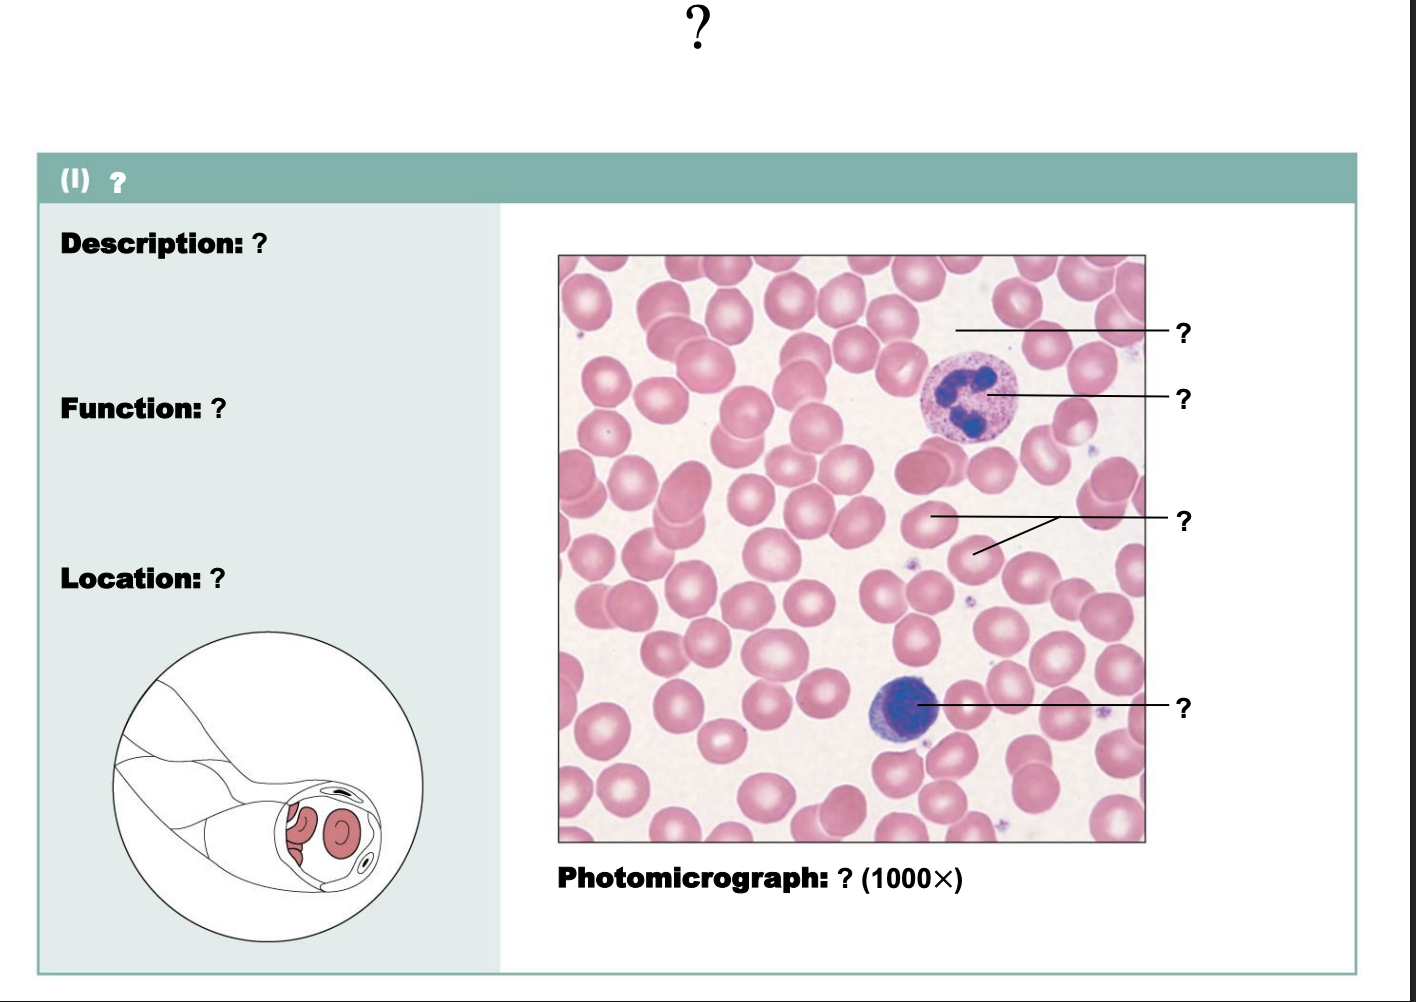
<p>location </p>

Connective tissues
1/65
There's no tags or description
Looks like no tags are added yet.
Name | Mastery | Learn | Test | Matching | Spaced | Call with Kai |
|---|
No analytics yet
Send a link to your students to track their progress
66 Terms
connective tissue functions
protect, support, bind
types of connective tissue
connective tissue proper
cartilage
bone
blood
types of muscle tissue
skeletal muscle
cardiac muscle
smooth muscle
connective tissue characteristics
rich blood supply
composed of many cell types
extracellular matrix

label left
macrophage
fibroblast
lymphocyte
fat cell
mast cell
neutrophil

label right
extracellular matrix
ground substance
fibers
collagen fiber
elastic fiber
reticular fiber

name
embryonic connective tissue: mesenchyme

description
embryonic connective tissue: mesenchyme- gel-like ground substance, star-shaped

function
embryonic connective tissue: mesenchyme- gives rise to all other connective tissue types

location
embryonic connective tissue: mesenchyme- embryo

label
fibers
ground substance
mesenchymal cell

name
connective tissue porper: loose connective tissue, areolar

description
connective tissue proper: loose connective tissue, areolar- gel-like matrix, three fiber types

function
connective tissue proper: loose connective tissue, areolar- wraps and cushions organ, role in inflammation

location
connective tissue proper: loose connective tissue, areolar- under epithelia, surrounds capillaries

label
collagen fibers
fibroblast nuclei
elastic fibers

name
connective tissue proper: loose connective tissue, adipose

description
connective tissue proper: loose connective tissue, adipose- matrix as in areolar, closely packed, nucleus pushed to side

function
connective tissue proper: loose connective tissue, adipose- reserve fuel, insulation, supports and protects organs

location
connective tissue proper: loose connective tissue, adipose- under skin, breast, abdomen

label
vacuole containing fat droplet
nuclei of fat cell

name
connective tissue proper: loose connective tissue, reticular

description
connective tissue proper: loose connective tissue, reticular- network of reticular fibers in loose ground substance

function
connective tissue proper: loose connective tissue, reticular- form soft internal skeleton, supports other cells

location
connective tissue proper: loose connective tissue, reticular- lymph nodes, bone marrow, spleen

name
connective tissue proper: dense connective tissue, dense regular

description
connective tissue proper: dense connective tissue, dense regular- fibroblasts, parallel collagen fibers, few elastic fibers

function
connective tissue proper: dense connective tissue, dense regular- attaches muscles to bones or mucles, bone to bone, withstand stress

location
connective tissue proper: dense connective tissue, dense regular- tendons, most ligaments

label
collagen fibers
nuclei of fibroblasts

name
connective tissue proper: dense connective tissue, dense irregular

descirption
connective tissue proper: dense connective tissue, dense irregular- irregularly arranged collagen fibers

function
connective tissue proper: dense connective tissue, dense irregular- withstand tension in many different directions, structural strength

location
connective tissue proper: dense connective tissue, dense irregular- fibrous capsules of organs, dermis, submucosa of digestive track

label
nuclei of fibroblasts
collagen fibers

name
connective tissue proper: dense connective tissue, elastic

description
high proportion of elastic fibers

function
connective tissue proper: dense connective tissue, elastic- recoil of tissue after stretch, flow of blood through arteries

location
connective tissue proper: dense connective tissue, elastic- walls of large arteries, walls of bronchial tubes

label
elastic fibers

name
cartilage: hyaline

description
hyaline cartilage- amorphous but firm matrix, imperceptible network

function
hyaline cartilage- supports and reinforces, resilient cushion

location
hyaline cartilage: embryonic skeleton, cover ends of long bones in join cavities

label
chondrocyte in lacuna
matrix

name
cartilage: elastic

description
elastic cartilage- similar to hyaline, more elastic fibers in matrix

function
elastic cartilage- maintain shape with flexibility

location
elastic cartilage- external ear, epiglottis

label
chondrocyte in lacuna
matrix

name
cartilage: fibrocartilage

description
fibrocartilage cartilage- matrix similar but less firm than hylaline, predominate thick collagen fibers

function
fibrocartilage cartilage- tensile strength, absorb compressive shock

location
fibrocartilage cartilage- intervertebral discs; disc of knee joint

label
chondrocytes in lacunae
collagen fiber

name
connective tissue: bone

description
connective tissue: bone- hard, calcified matrix, many collagen fibers

function
connective tissue: bone- support and protect, stores calcium and fats and other minerals, blood cell formation

location
connective tissue: bones- bones

label
central canal
lacunae
lamella

name
connective tissue: blood

description
connective tissue: blood- red and white blood cells in fluid matrix

function
connective tissue: blood- transport of respiratory gases, nutrient, wastes
location
connective tissue: blood- blood vessles

label
plasma
neutrophil
red blood cells
lymphocyte